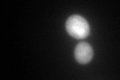

View description
Ubiquitin, becomes conjugated to proteins, marking them for selective degradation via the ubiquitin-26S proteasome system; essential for the cellular stress response; encoded as a polyubiquitin precursor comprised of 5 head-to-tail repeats
Localization:
Intensity:
Fold change:
Significance:
-
C’ GFP library in SD

cytosol46.71 -
N' NOP1pr-GFP in SD

punctate71.3391 -
N' TEF2pr-mCherry in SD

punctate6.56542 -
N' NATIVEpr-GFP in SD

punctate74.2582 -
N' TEF2pr-VC and Cyto-VN in SD

#N/A0 -
C’ GFP library in SD+DTT
cytosol126.82.71Yes -
C’ GFP library in SD+H2O2

cytosol87.171.86Yes -
C’ GFP library in Starvation Media

cytosol69.911.49Yes -
C’ GFP library on the background of Pup2-DaMP

cytosol -
C’ GFP library on the background of CCT mutant

cytosol53.22731.13927No
